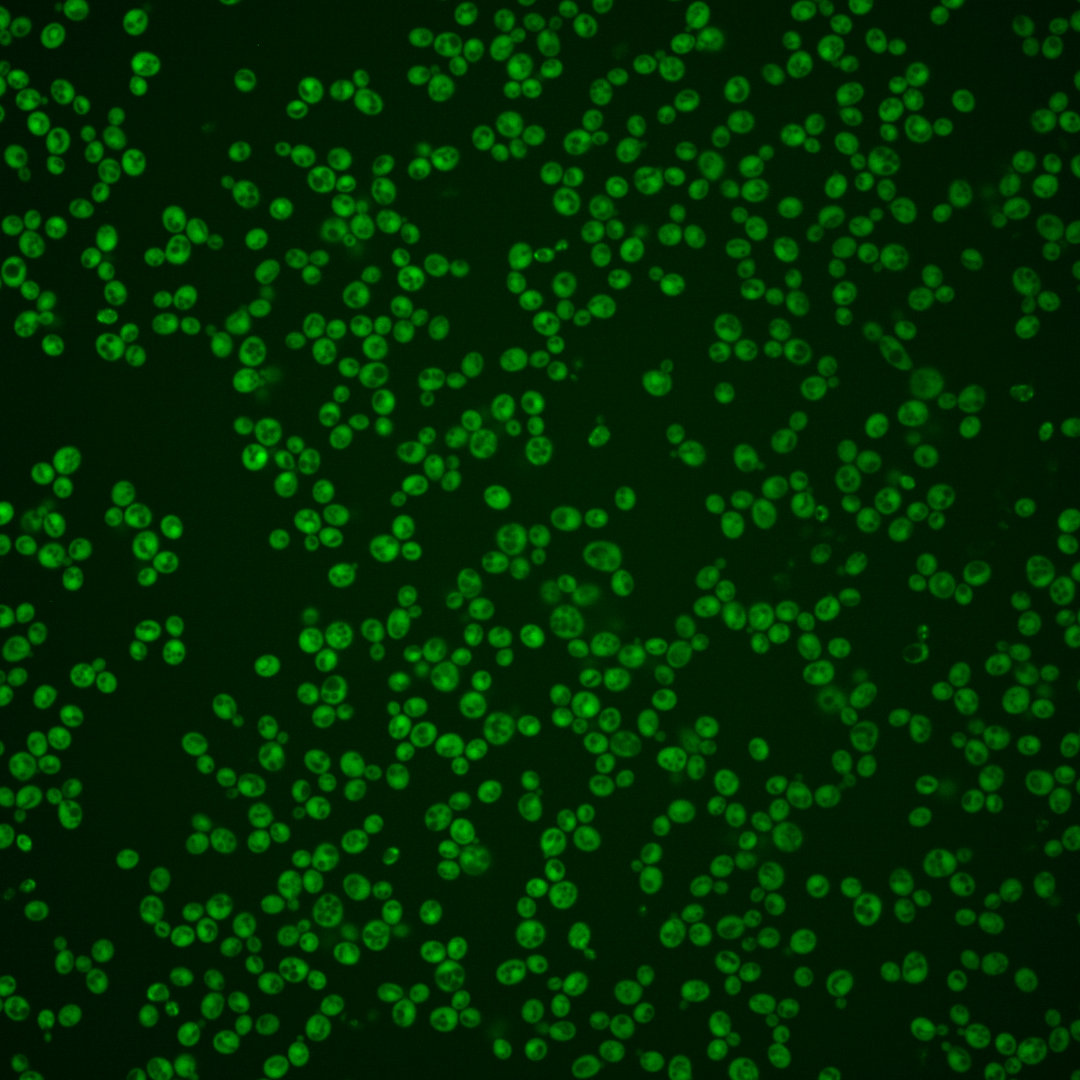
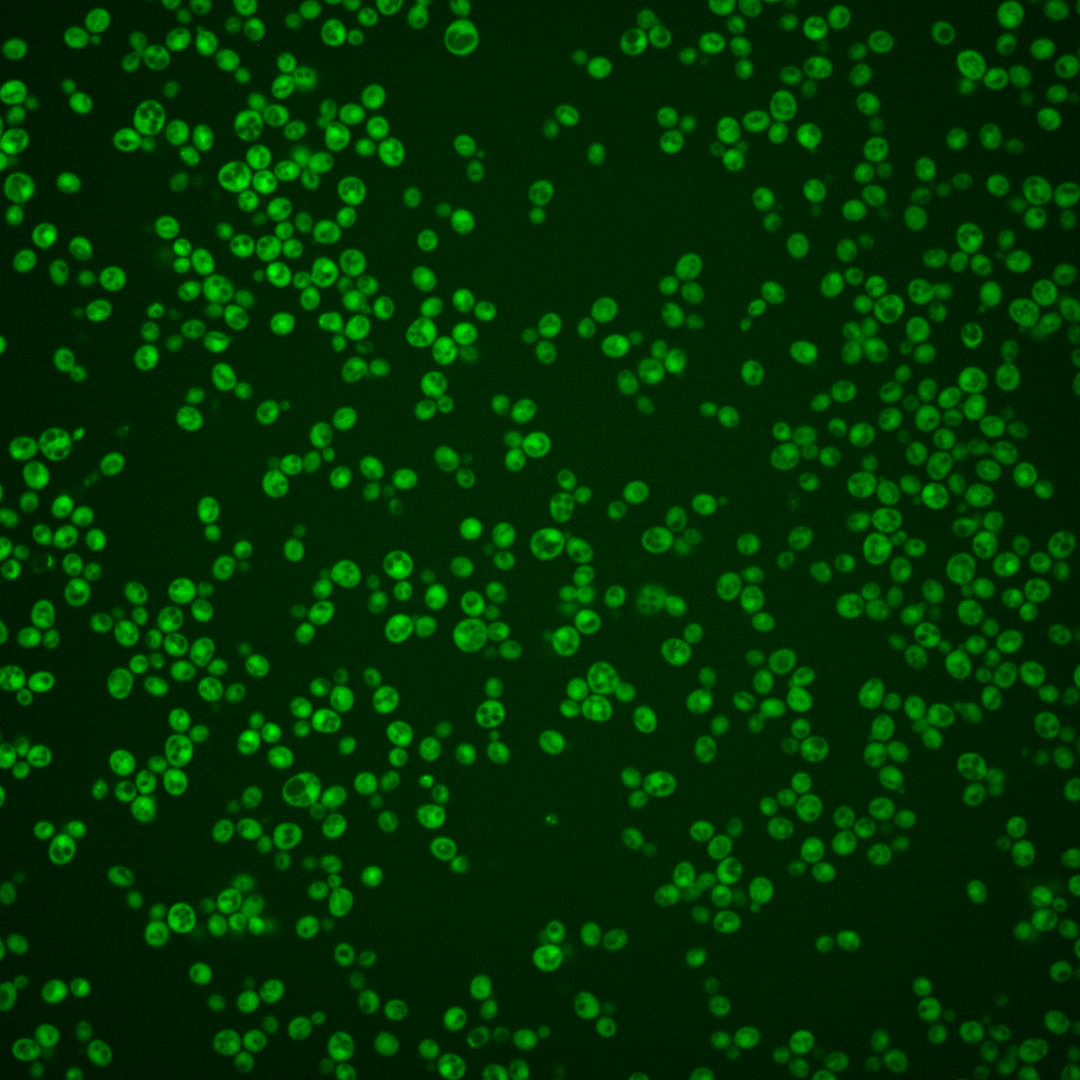
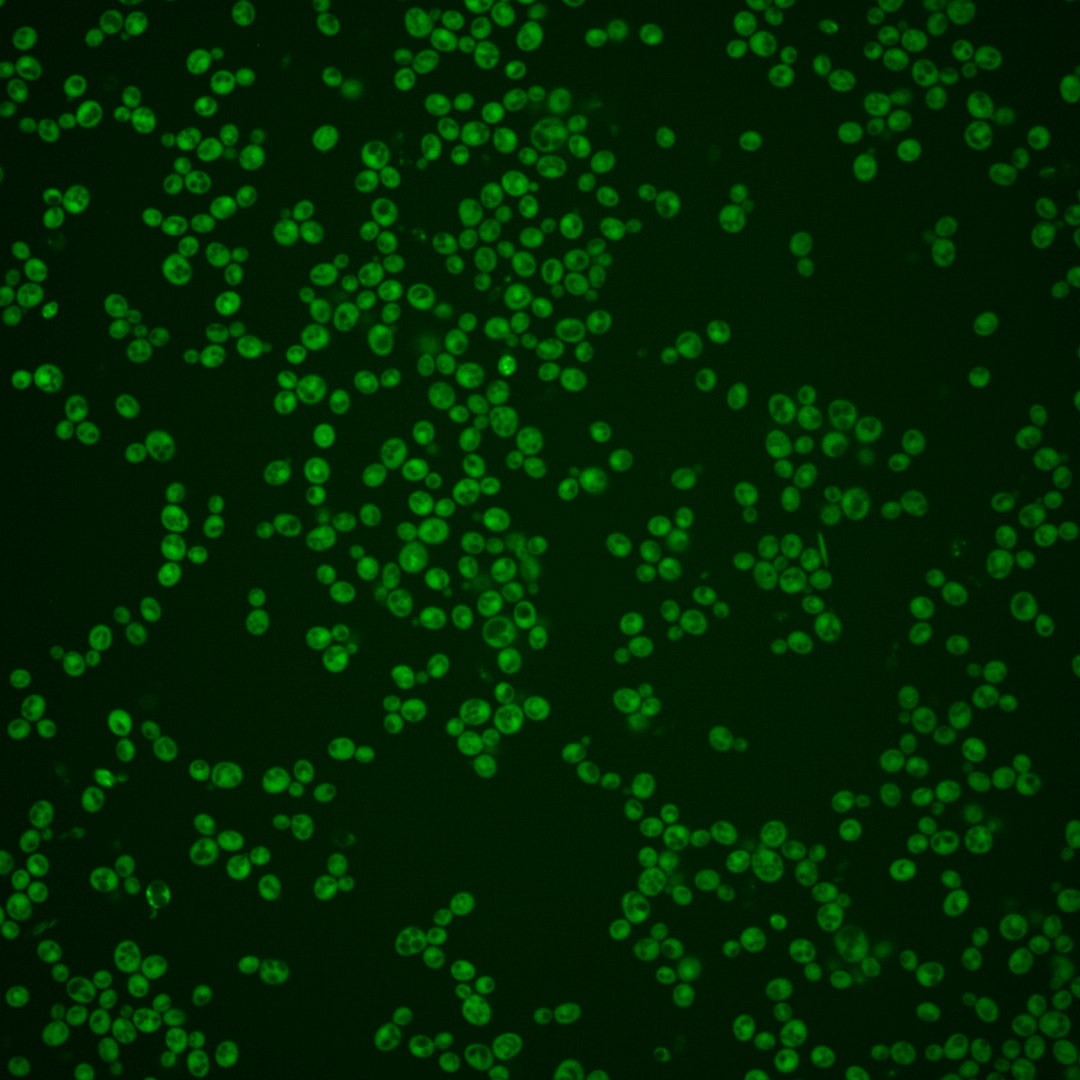
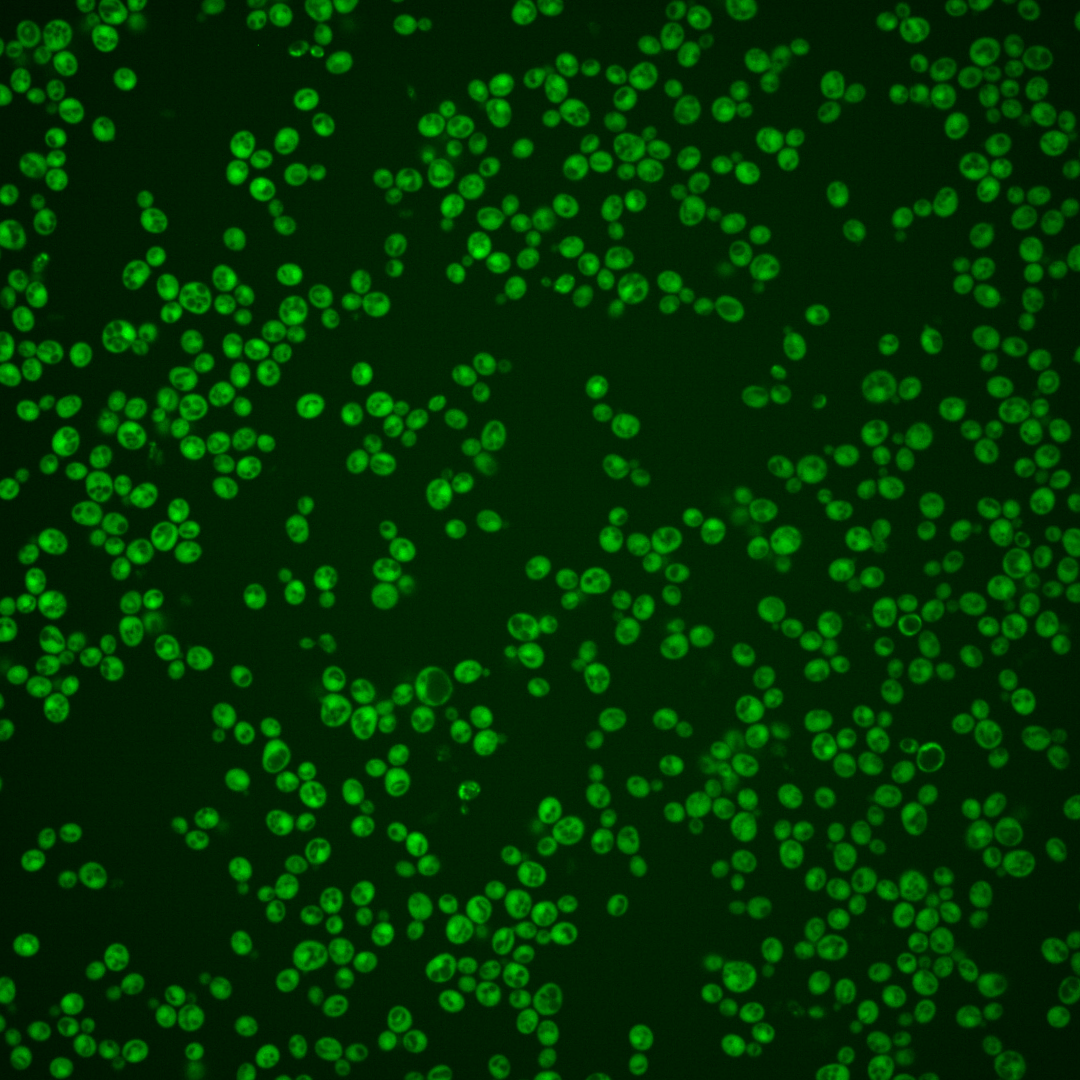
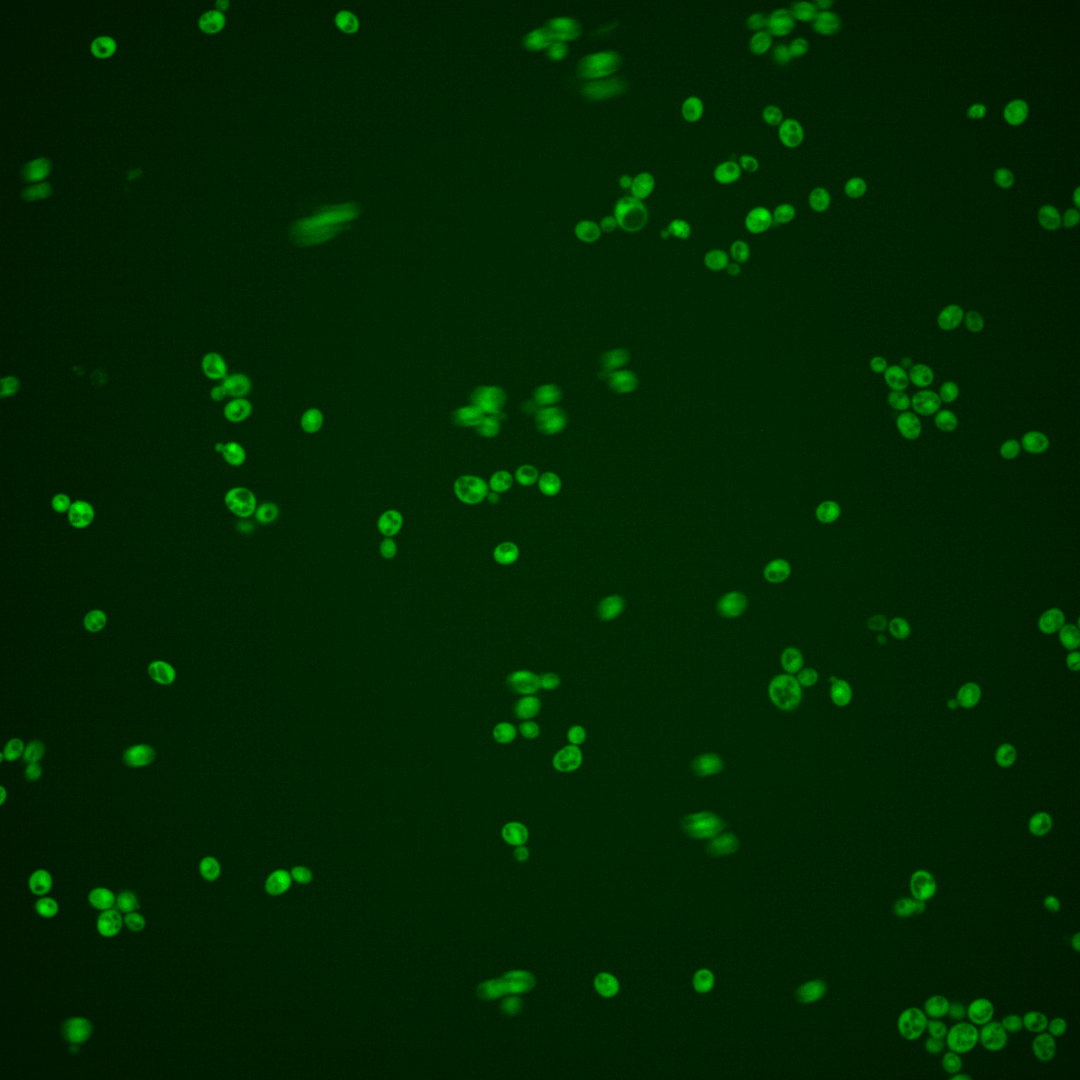

| Standard name | |
|---|---|
| Human Ortholog | |
| Description | Inositol monophosphatase; involved in biosynthesis of inositol and in phosphoinositide second messenger signaling; INM1 expression increases in the presence of inositol and decreases upon exposure to antibipolar drugs lithium and valproate |
Micrographs




















































































Sub-cellular Localization
Yeast GFP Assignment
Protein Abundance
Localization Change
External localization resources
| ensLOC | DeepLoc | |||||||||||||||||||||||
|---|---|---|---|---|---|---|---|---|---|---|---|---|---|---|---|---|---|---|---|---|---|---|---|---|
| Localization | WT1 | WT2 | WT3 | RAP60 | RAP140 | RAP220 | RAP300 | RAP380 | RAP460 | RAP540 | RAP620 | RAP700 | HU80 | HU120 | HU160 | rpd3Δ_1 | rpd3Δ_2 | rpd3Δ_3 | WT1 | WT2 | WT3 | AF100 | AF140 | AF180 |
| Cortical Patches | 0 | 0 | 0 | 0 | 0 | 0 | 0 | 0 | 0 | 0 | 0 | 0 | 0 | 0 | 0 | 0 | 0 | 0 | 1 | 0 | 0 | 0 | 0 | 1 |
| Bud | 0 | 1 | 0 | 0 | 0 | 0 | 0 | 1 | 1 | 1 | 3 | 2 | 0 | 0 | 0 | 0 | 0 | 0 | 0 | 0 | 0 | 1 | 2 | 2 |
| Bud Neck | 0 | 0 | 0 | 0 | 0 | 0 | 0 | 0 | 0 | 0 | 0 | 0 | 0 | 0 | 0 | 0 | 0 | 0 | 0 | 0 | 0 | 0 | 0 | 1 |
| Bud Site | 0 | 0 | 0 | 0 | 0 | 0 | 0 | 0 | 0 | 0 | 0 | 0 | 0 | 0 | 0 | 0 | 0 | 0 | – | – | – | – | – | – |
| Cell Periphery | 0 | 1 | 0 | 0 | 2 | 3 | 2 | 1 | 1 | 4 | 0 | 3 | 0 | 1 | 0 | 1 | 2 | 4 | 0 | 0 | 0 | 0 | 0 | 0 |
| Cytoplasm | 119 | 392 | 168 | 110 | 198 | 204 | 237 | 229 | 165 | 215 | 94 | 79 | 181 | 329 | 335 | 341 | 411 | 251 | 121 | 396 | 165 | 205 | 231 | 264 |
| Endoplasmic Reticulum | 1 | 0 | 0 | 1 | 1 | 3 | 1 | 1 | 1 | 0 | 0 | 6 | 3 | 1 | 0 | 14 | 19 | 7 | 1 | 0 | 0 | 2 | 1 | 0 |
| Endosome | 0 | 0 | 0 | 0 | 0 | 0 | 1 | 0 | 0 | 1 | 0 | 0 | 0 | 0 | 1 | 4 | 3 | 3 | 4 | 0 | 0 | 0 | 1 | 1 |
| Golgi | 0 | 0 | 0 | 0 | 0 | 0 | 0 | 0 | 0 | 0 | 0 | 0 | 0 | 0 | 0 | 0 | 2 | 0 | 0 | 0 | 0 | 0 | 0 | 0 |
| Mitochondria | 1 | 1 | 0 | 1 | 0 | 5 | 21 | 12 | 83 | 74 | 57 | 57 | 0 | 1 | 0 | 10 | 4 | 2 | 0 | 2 | 0 | 3 | 4 | 6 |
| Nucleus | 0 | 2 | 0 | 1 | 1 | 5 | 4 | 8 | 4 | 5 | 1 | 2 | 0 | 1 | 0 | 3 | 1 | 8 | 1 | 2 | 0 | 3 | 1 | 3 |
| Nuclear Periphery | 0 | 0 | 0 | 0 | 0 | 0 | 0 | 0 | 2 | 1 | 0 | 0 | 0 | 0 | 0 | 0 | 0 | 0 | 0 | 0 | 0 | 0 | 1 | 0 |
| Nucleolus | 0 | 0 | 0 | 0 | 0 | 0 | 0 | 1 | 0 | 0 | 0 | 0 | 0 | 0 | 0 | 0 | 0 | 0 | 0 | 0 | 0 | 0 | 0 | 0 |
| Peroxisomes | 0 | 0 | 0 | 0 | 0 | 0 | 0 | 0 | 0 | 0 | 0 | 0 | 0 | 0 | 0 | 1 | 0 | 0 | 0 | 0 | 0 | 0 | 0 | 0 |
| SpindlePole | 0 | 0 | 0 | 0 | 0 | 0 | 0 | 1 | 0 | 0 | 0 | 0 | 0 | 0 | 0 | 0 | 1 | 0 | 1 | 0 | 0 | 0 | 0 | 0 |
| Vac/Vac Membrane | 0 | 2 | 4 | 4 | 10 | 3 | 7 | 18 | 19 | 15 | 4 | 1 | 7 | 1 | 6 | 35 | 33 | 34 | 0 | 2 | 0 | 3 | 1 | 2 |
| Unique Cell Count | 121 | 396 | 171 | 116 | 206 | 216 | 262 | 257 | 232 | 276 | 130 | 121 | 185 | 329 | 335 | 369 | 436 | 277 | 136 | 408 | 170 | 223 | 251 | 290 |
| Labelled Cell Count | 121 | 399 | 172 | 117 | 212 | 223 | 273 | 272 | 276 | 316 | 159 | 150 | 191 | 334 | 342 | 409 | 476 | 309 | 136 | 408 | 170 | 223 | 251 | 290 |
Yeast GFP Assignment
Protein Abundance
| Screen | WT1 | WT2 | WT3 | RAP60 | RAP140 | RAP220 | RAP300 | RAP380 | RAP460 | RAP540 | RAP620 | RAP700 | HU80 | HU120 | HU160 | rpd3Δ_1 | rpd3Δ_2 | rpd3Δ_3 | AF100 | AF140 | AF180 |
|---|---|---|---|---|---|---|---|---|---|---|---|---|---|---|---|---|---|---|---|---|---|
| Mean Cell GFP Intensity (1e-4) | 9.1 | 6.9 | 9.8 | 8.9 | 8.8 | 6.3 | 6.1 | 6.0 | 4.8 | 5.1 | 4.5 | 4.4 | 9.6 | 9.2 | 8.7 | 8.3 | 10.7 | 11.3 | 9.3 | 9.8 | 9.6 |
| Std Deviation (1e-4) | 1.7 | 1.1 | 1.7 | 1.8 | 1.6 | 0.9 | 1.7 | 1.3 | 1.1 | 1.3 | 0.7 | 0.6 | 1.8 | 1.6 | 1.6 | 1.5 | 2.1 | 2.3 | 2.1 | 2.4 | 2.2 |
| Intensity Change (Log2) | – | – | – | -0.14 | -0.16 | -0.64 | -0.7 | -0.72 | -1.05 | -0.96 | -1.12 | -1.16 | -0.04 | -0.09 | -0.18 | -0.25 | 0.13 | 0.2 | -0.08 | -0.01 | -0.03 |
Localization Change
| Localization | RAP60 | RAP140 | RAP220 | RAP300 | RAP380 | RAP460 | RAP540 | RAP620 | RAP700 | HU80 | HU120 | HU160 | rpd3Δ_1 | rpd3Δ_2 | rpd3Δ_3 |
|---|---|---|---|---|---|---|---|---|---|---|---|---|---|---|---|
| Cortical Patches | 0 | 0 | 0 | 0 | 0 | 0 | 0 | 0 | 0 | 0 | 0 | 0 | 0 | 0 | 0 |
| Bud | 0 | 0 | 0 | 0 | 0 | 0 | 0 | 0 | 0 | 0 | 0 | 0 | 0 | 0 | 0 |
| Bud Neck | 0 | 0 | 0 | 0 | 0 | 0 | 0 | 0 | 0 | 0 | 0 | 0 | 0 | 0 | 0 |
| Bud Site | 0 | 0 | 0 | 0 | 0 | 0 | 0 | 0 | 0 | 0 | 0 | 0 | 0 | 0 | 0 |
| Cell Periphery | 0 | 0 | 0 | 0 | 0 | 0 | 0 | 0 | 0 | 0 | 0 | 0 | 0 | 0 | 0 |
| Cytoplasm | -1.6 | -1.2 | -1.9 | -3.2 | -3.6 | -7.1 | -6.0 | -6.6 | -7.7 | -0.3 | 2.4 | 2.4 | -2.7 | -2.1 | -3.2 |
| Endoplasmic Reticulum | 0 | 0 | 0 | 0 | 0 | 0 | 0 | 0 | 0 | 0 | 0 | 0 | 0 | 2.8 | 0 |
| Endosome | 0 | 0 | 0 | 0 | 0 | 0 | 0 | 0 | 0 | 0 | 0 | 0 | 0 | 0 | 0 |
| Golgi | 0 | 0 | 0 | 0 | 0 | 0 | 0 | 0 | 0 | 0 | 0 | 0 | 0 | 0 | 0 |
| Mitochondria | 0 | 0 | 0 | 3.8 | 0 | 0 | 7.4 | 0 | 0 | 0 | 0 | 0 | 0 | 0 | 0 |
| Nucleus | 0 | 0 | 0 | 0 | 0 | 0 | 0 | 0 | 0 | 0 | 0 | 0 | 0 | 0 | 0 |
| Nuclear Periphery | 0 | 0 | 0 | 0 | 0 | 0 | 0 | 0 | 0 | 0 | 0 | 0 | 0 | 0 | 0 |
| Nucleolus | 0 | 0 | 0 | 0 | 0 | 0 | 0 | 0 | 0 | 0 | 0 | 0 | 0 | 0 | 0 |
| Peroxisomes | 0 | 0 | 0 | 0 | 0 | 0 | 0 | 0 | 0 | 0 | 0 | 0 | 0 | 0 | 0 |
| SpindlePole | 0 | 0 | 0 | 0 | 0 | 0 | 0 | 0 | 0 | 0 | 0 | 0 | 0 | 0 | 0 |
| Vacuole | 0 | 1.3 | 0 | 0 | 2.1 | 2.5 | 1.6 | 0 | 0 | 0.8 | 0 | 0 | 3.0 | 2.4 | 3.7 |
External localization resources
Images






























Protein Concentration and Protein Localization Data
| R1 | R2 | R3 | ||||||||||||||||
|---|---|---|---|---|---|---|---|---|---|---|---|---|---|---|---|---|---|---|
| G1 Pre-START | G1 Post-START | S/G2 | Metaphase | Anaphase | Telophase | G1 Pre-START | G1 Post-START | S/G2 | Metaphase | Anaphase | Telophase | G1 Pre-START | G1 Post-START | S/G2 | Metaphase | Anaphase | Telophase | |
| Concentration | 7.9406 | 10.0686 | 8.5734 | 7.4433 | 7.2723 | 8.5251 | 5.8138 | 8.5793 | 7.2194 | 6.6756 | 6.0442 | 7.2008 | 3.9495 | 6.7107 | 5.6036 | 5.106 | 4.6682 | 5.8774 |
| Actin | 0.0233 | 0.0008 | 0.0055 | 0.0003 | 0.0236 | 0.0063 | 0.019 | 0.0016 | 0.0317 | 0.0015 | 0.0036 | 0.0009 | 0.0453 | 0.0002 | 0.0115 | 0.0295 | 0.044 | 0.0051 |
| Bud | 0.0003 | 0.0001 | 0.0002 | 0.0001 | 0.0052 | 0.0002 | 0.0004 | 0.0002 | 0.0031 | 0.0001 | 0.0002 | 0.0002 | 0.0005 | 0.0001 | 0.001 | 0.0002 | 0.0011 | 0.0003 |
| Bud Neck | 0.01 | 0.0002 | 0.0004 | 0.0004 | 0.0016 | 0.0018 | 0.0005 | 0.0063 | 0.0012 | 0.0007 | 0.0004 | 0.001 | 0.0023 | 0.0002 | 0.0053 | 0.001 | 0.0089 | 0.0019 |
| Bud Periphery | 0.0003 | 0 | 0.0001 | 0 | 0.0019 | 0.0002 | 0.0003 | 0.0002 | 0.0048 | 0 | 0.0002 | 0.0001 | 0.0006 | 0 | 0.0011 | 0.0001 | 0.0013 | 0.0002 |
| Bud Site | 0.0016 | 0.0006 | 0.0008 | 0.0002 | 0.0008 | 0.0002 | 0.0023 | 0.0109 | 0.0109 | 0.0002 | 0.0004 | 0.0001 | 0.0048 | 0.0002 | 0.0056 | 0.0014 | 0.0221 | 0.0002 |
| Cell Periphery | 0.0002 | 0.0001 | 0.0001 | 0 | 0.0002 | 0 | 0.0001 | 0.0001 | 0.0004 | 0 | 0.0001 | 0 | 0.0003 | 0 | 0.0002 | 0 | 0.0007 | 0 |
| Cytoplasm | 0.8469 | 0.9714 | 0.9237 | 0.9322 | 0.8207 | 0.9428 | 0.9178 | 0.9442 | 0.8533 | 0.9663 | 0.8318 | 0.9423 | 0.7355 | 0.9848 | 0.8981 | 0.8999 | 0.7343 | 0.9405 |
| Cytoplasmic Foci | 0.0163 | 0.0018 | 0.0078 | 0.002 | 0.0148 | 0.0056 | 0.006 | 0.0036 | 0.0123 | 0.0036 | 0.012 | 0.0034 | 0.0459 | 0.0013 | 0.0106 | 0.0216 | 0.0141 | 0.0112 |
| Eisosomes | 0.0002 | 0 | 0.0001 | 0 | 0.0009 | 0 | 0 | 0 | 0.0001 | 0 | 0 | 0 | 0.0004 | 0 | 0.0001 | 0.0001 | 0.0007 | 0 |
| Endoplasmic Reticulum | 0.0048 | 0.002 | 0.0024 | 0.0022 | 0.0048 | 0.0022 | 0.0052 | 0.0006 | 0.003 | 0.0019 | 0.0073 | 0.0017 | 0.0065 | 0.001 | 0.0046 | 0.0009 | 0.0074 | 0.0014 |
| Endosome | 0.0115 | 0.0006 | 0.0054 | 0.0007 | 0.0341 | 0.0017 | 0.0022 | 0.001 | 0.0191 | 0.0007 | 0.069 | 0.0014 | 0.0295 | 0.0004 | 0.009 | 0.0097 | 0.0482 | 0.004 |
| Golgi | 0.0069 | 0.0003 | 0.0021 | 0.0001 | 0.015 | 0.0003 | 0.001 | 0.0009 | 0.0099 | 0.0001 | 0.02 | 0.0001 | 0.011 | 0 | 0.007 | 0.0024 | 0.0257 | 0.0034 |
| Lipid Particles | 0.0044 | 0.0001 | 0.001 | 0 | 0.0148 | 0.0001 | 0.0004 | 0.0001 | 0.0008 | 0 | 0.0063 | 0 | 0.0291 | 0 | 0.0049 | 0.0022 | 0.0228 | 0.0007 |
| Mitochondria | 0.0015 | 0.0001 | 0.0024 | 0.0002 | 0.019 | 0.0003 | 0.0002 | 0.0002 | 0.0079 | 0.0002 | 0.0035 | 0.0002 | 0.0045 | 0.0001 | 0.0048 | 0.0005 | 0.0159 | 0.0016 |
| None | 0.0457 | 0.0103 | 0.0318 | 0.0214 | 0.011 | 0.0147 | 0.0374 | 0.0251 | 0.0263 | 0.0156 | 0.0174 | 0.0396 | 0.0133 | 0.0033 | 0.006 | 0.0028 | 0.0031 | 0.0032 |
| Nuclear Periphery | 0.0054 | 0.0009 | 0.0011 | 0.0023 | 0.0065 | 0.0016 | 0.0014 | 0.0004 | 0.0014 | 0.0009 | 0.014 | 0.0009 | 0.0143 | 0.0008 | 0.0029 | 0.0017 | 0.0143 | 0.001 |
| Nucleolus | 0.0004 | 0 | 0 | 0 | 0.0002 | 0 | 0 | 0 | 0.0001 | 0 | 0.0002 | 0 | 0.0006 | 0 | 0.0015 | 0.0001 | 0.0006 | 0.0001 |
| Nucleus | 0.0084 | 0.01 | 0.0089 | 0.0367 | 0.014 | 0.0197 | 0.0034 | 0.0031 | 0.0079 | 0.0069 | 0.0063 | 0.0069 | 0.0191 | 0.0069 | 0.0114 | 0.0161 | 0.0144 | 0.0129 |
| Peroxisomes | 0.0035 | 0 | 0.005 | 0 | 0.0062 | 0.0011 | 0.001 | 0.0009 | 0.0016 | 0.0001 | 0.0008 | 0.0001 | 0.0257 | 0.0001 | 0.0083 | 0.0032 | 0.0107 | 0.0104 |
| Punctate Nuclear | 0.0071 | 0.0004 | 0.0006 | 0.0008 | 0.0017 | 0.0007 | 0.0007 | 0.0003 | 0.0007 | 0.0009 | 0.003 | 0.0005 | 0.0081 | 0.0003 | 0.0047 | 0.006 | 0.0037 | 0.0011 |
| Vacuole | 0.0009 | 0.0004 | 0.0005 | 0.0003 | 0.0017 | 0.0007 | 0.0006 | 0.0002 | 0.003 | 0.0002 | 0.0019 | 0.0004 | 0.0016 | 0.0003 | 0.0011 | 0.0005 | 0.0031 | 0.0005 |
| Vacuole Periphery | 0.0003 | 0 | 0.0001 | 0.0001 | 0.0012 | 0.0001 | 0.0001 | 0 | 0.0005 | 0 | 0.0015 | 0.0001 | 0.0009 | 0 | 0.0003 | 0.0001 | 0.0029 | 0.0001 |
Sequencing Data
| R1 | R2 | |||||||||
|---|---|---|---|---|---|---|---|---|---|---|
| G1 Post-START | S/G2 | Metaphase | Anaphase | Telophase | G1 Post-START | S/G2 | Metaphase | Anaphase | Telophase | |
| Gene Expression | 8.698 | 7.7755 | 18.1335 | 19.1453 | 20.9436 | 9.9351 | 16.8467 | 21.6037 | 20.7734 | 15.5244 |
| Translational Efficiency | 2.8752 | 3.641 | 1.7596 | 1.9481 | 1.1313 | 2.8798 | 2.1833 | 1.6493 | 1.6139 | 2.1336 |
Hit Data
| Dataset | Hit |
|---|---|
| Protein Concentration | ✘ |
| Protein Localization | ✘ |
| Gene Expression | ✘ |
| Translational Efficiency | ✘ |
Endocytosis
| Temp | Actin Patch (Sac6-tdTomato) | Cortical Patch (Sla1-GFP) | Late Endosome (Snf7-GFP) | Vacuole (Vph1-GFP) |
|---|---|---|---|---|
| 37℃ | ||||
| RT |
Cell Cycle Omics
CYCLoPs (Inm1-GFP)
| Gene / Allele | Actin Patch (Sac6-tdTomato) | Cortical Patch (Sla1-GFP) | Late Endosome (Snf7-GFP) | Vacuole (Sac6-tdTomato) |
|---|
| Gene | Images |
|---|
| Gene | Images |
|---|
Images are not yet available
Images are not yet available